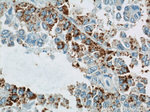
GUF1 Antibody in Immunohistochemistry (Paraffin) (IHC (P))
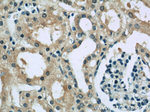
GUF1 Antibody in Immunohistochemistry (Paraffin) (IHC (P))

Search
Proteintech
GUF1 Polyclonal Antibody
{{$productOrderCtrl.translations['antibody.pdp.commerceCard.promotion.promotions']}}
{{$productOrderCtrl.translations['antibody.pdp.commerceCard.promotion.viewpromo']}}
{{$productOrderCtrl.translations['antibody.pdp.commerceCard.promotion.promocode']}}: {{promo.promoCode}} {{promo.promoTitle}} {{promo.promoDescription}}. {{$productOrderCtrl.translations['antibody.pdp.commerceCard.promotion.learnmore']}}
产品信息
17489-1-AP
种属反应
宿主/亚型
分类
类型
抗原
偶联物
形式
浓度
规格
纯化类型
保存液
内含物
保存条件
运输条件
产品详细信息
Immunogen sequence: VGYLIAGMK DVTEAQIGDT LCLHKQPVEP LPGFKSAKPM VFAGMYPLDQ SEYNNLKSAI EKLTLNDSSV TVHRDSSLAL GAGWRLGFLG LLHMEVFNQR LEQEYNASVI LTTPTVPYKA VLSSSKLIKE HREKEITIIN PAQFPDKSKV TEYLEPVVLG TIITPDEYTG KIMMLCEARR AVQKNMIFID QNRVMLKYLF PLNEIVVDFY DSLKSLSSGY ASFDYEDAGY QTAELVKMDI LLNGNTVEEL VTVVHKDKAH SIGKAICERL KDSLPRQLFE IAIQAAIGSK IIARETVKAY RKNVLAKCYG GDITRKMKLL KRQAEGKKKL RKIGNVEVPK DAFIKVLKTQ SSK (318-669 aa encoded by BC036768)
靶标信息
Promotes mitochondrial protein synthesis. May act as a fidelity factor of the translation reaction, by catalyzing a one- codon backward translocation of tRNAs on improperly translocated ribosomes. Binds to mitochondrial ribosomes in a GTP-dependent manner.
仅用于科研。不用于诊断过程。未经明确授权不得转售。
篇参考文献 (0)
生物信息学
蛋白别名: EF-4; Elongation factor 4 homolog; GTP-binding protein GUF1 homolog; GTPase GUF1; GTPase of unknown function 1; GUF1 homolog, GTPase; Ribosomal back-translocase; Translation factor GUF1, mitochondrial; unnamed protein product
基因别名: 4631409J12; AA407526; DEE40; EF-4; EF4; EIEE40; GUF1
UniProt ID: (Human) Q8N442, (Mouse) Q8C3X4
Entrez Gene ID: (Human) 60558, (Mouse) 231279